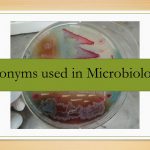
List of acronyms most commonly used in Microbiology

Collection Group: Clinical Bacteriology
Christensen Urea Agar : Composition, Preparation and Uses
 Christensen Urea Agar (Oxoid, England) Christensen urea agar is a...
Christensen Urea Agar (Oxoid, England) Christensen urea agar is a...
Indole test: Introduction, Principle, Procedure and Result Interpretation
 Indole Production test This indole test is useful to identify...
Indole Production test This indole test is useful to identify...
List of Acronyms Most Commonly Used in Microbiology and Its Related Fields
List of Acronyms Most Commonly Used in Microbiology There is...
List of Acronyms Most Commonly Used in Microbiology There is...
